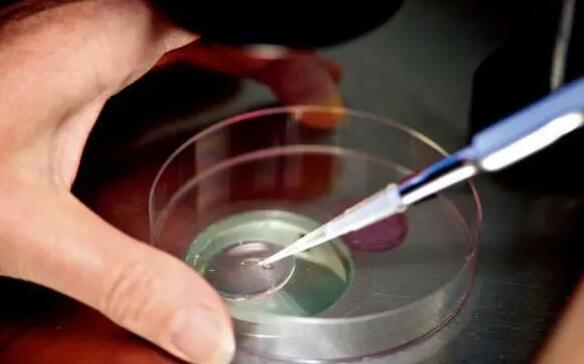
安徽排名前五的三代试管婴儿医院有哪些？附详细信息

-

广州三代试管代生包性别机构排名?附详细信息?
广州三代试管代生包性别机构排名?附详细信息?第三代试管婴儿技术可以进行基因诊断和筛查,发现大部分疾病和遗传性疾病,实现优生优育。随着我国试管婴儿医疗技术的发展,..
2023-03-25 12:37 -

湖南试管代怀公司排名如何?附详细信息?
湖南试管代怀公司排名如何?附详细公司信息?到2020年12月,湖南长沙有7家医院可以开展试管婴儿技术,其中公立6家,私立1家。这里说的民营医院都是正规的民营试管婴儿医院..
2023-03-25 12:41 -

杭州三代试管代怀中心排名哪家强?附详细信息?
杭州三代试管代怀中心排名哪家强?附详细信息?浙江省有27家医院可以做试管婴儿,其中9家在杭州。杭州有很多医院可以做试管婴儿,选择很多。所以很多不孕不育家庭去浙江省..
2023-03-25 12:49 -

深圳能做试管包男孩的两家医院是哪两家?附详细信息?
深圳能做试管包男孩的两家医院是哪两家?附详细信息?根据国家卫健委最新发布的相关文件,广东省深圳市目前有7家医院可以开展试管婴儿技术,其中2家具备三代试管婴儿资质。..
2023-07-11 10:35 -

昆明供卵二代试管婴儿包生男孩医院排名?附详细信息?
昆明供卵包医院排名?附详细信息?昆明市有11家医院可以开展生殖辅助技术,包括昆华医院、昆明二附院、昆明市妇幼保健院等。至于能不能进行二代试管婴儿技术,可以咨询这些..
2023-07-20 11:32 -
安徽排名前五的三代试管婴儿医院有哪些?附详细信息
安徽排名前五的三代试管婴儿医院有哪些?附详细信息。体外受精结合胚胎移植(IVF):也叫试管受精,是指将卵子和精子分别取出,放入试管中进行受精,然后将胚胎前体受精卵转回..
2023-08-06 11:12 -

广东第三代试管婴儿生男孩医院排名?附详细信息?
广东第医院排名?附详细信息?广东医疗水平参差不齐,但综合实力毋庸置疑。很多北方人会去广东做试管婴儿。今天就和大家分享一下广东第三代名单。让我们来看看!1.广州(1)..
2023-08-12 12:59 -

长春能生男孩的第三代试管婴儿医院排名前十的有哪些?附详细信息
长春能的第三代试管婴儿医院排名前十的有哪些?附详细信息。到2022年初,长春有5家医院开展了辅助生殖技术,其中1家只能开展技术。目前长春妇产医院、吉林大学第二医院、吉..
2023-08-18 11:49 -

福建第三代试管婴儿医院生男孩排名费用?附详细信息?
福建第三代试管婴儿医院排名费用?附详细信息?对于福建本地的试管婴儿家庭来说,福建的排名是他们关注的重点,因为80%以上的试管婴儿都是在医院进行的。选择排名靠前的试..
2023-08-19 11:05 -

天津第三代供卵包男孩试管婴儿医院哪家强?附详细信息?
天津第三代试管婴儿供卵包男孩试管婴儿医院哪家强?附详细信息?随着三孩政策的正式实施,许多家庭开始响应国家政策。那么天津最权威的试管婴儿医院是哪家呢?能做第三代试..
2023-08-22 12:20 -

上海第三代供卵试管婴儿生男孩医院排名发布?附详细信息?
上海第三代试管婴儿供卵医院排名发布?附详细信息?在很多试管家庭看来,试管婴儿的费用就像是知道了一个间隔或者细节就吃了一颗定心丸。今天就给大家讲讲上海十大以及费用..
2023-08-23 12:41 -

保定试管婴儿医院排名前十的有哪些?附详细信息
保定试管婴儿医院排名前十的有哪些?附详细信息。保定有三家试管婴儿医院,分别是保定市妇幼医院、河北大学附属医院和涿州医院。大部分集中在莲池区,涿州市也有一个。其他..
2023-09-26 18:13 -

湖南十大第二代试管婴儿医院生男孩排名?附详细信息?
湖南十大排名?附详细信息?来了解一下为了让国人更便捷地享受国内外优质的试管婴儿医疗服务,湖南十大试管婴儿医院排名好的,有哪些?医院前10名分别是长沙中信湘雅医院、..
2023-10-13 19:26 -

中国可以借卵试管婴儿生男孩的医院排名?附详细信息?
中国可以借卵试管婴儿生男孩的医院排名?附详细信息?公医院分布在北京、上海、天津、重庆、河北、浙江。卵子供应不像捐精一样有专门的储存处。如果想做供试管,可以参考医..
2024-07-23 09:19 -
昆明正规借卵试管医院排名名单?附详细信息?
昆明正规借卵试管医院排名名单?附详细信息?如今试管婴儿技术已经越来越先。在很多地区都有一些很有特色的专门做试管的医院,都是以试管成功率来吸引眼球的。在不同的城市..
2024-07-27 09:50 -

保定第三代试管婴儿医院排名前十的有哪些?附详细信息
保定排名前十的有哪些?附详细信息。保定有三家试管婴儿医院,分别是保定市妇幼医院、河北大学附属医院和涿州医院。大部分集中在莲池区,涿州市也有一个。其他城区虽然有很..
2024-10-21 09:52 -
济南不孕不育借卵试管医院排名?附详细信息?
济南不孕不育借卵试管医院排名?附详细信息?例假的周期一直不正常,基本都是延迟。有时候拖一周,有时候拖半个多月。长的法定假日超过50天。去年年初,我开始准备怀孕。怀孕..
2025-02-09 09:16 -

山东能做供卵三代试管婴儿选男孩的医院排名?附详细信息?
山东能做供卵三代试管婴儿选男孩的医院排名?附详细信息?山东省是中国的人口大省。截至2020年4月,本省有31家医院有资格开展辅助生殖技术,其中有26家医院有资格开展。这2..
2025-10-16 10:23 -

湖北供卵三代试管婴儿包成功医院排行名单?附详细信息?
湖北供卵三代试管婴儿包成功医院排行名单?附详细信息?截至2022年9月24日,已知湖北有多家三代试管婴儿医院可以供应卵子。这些供卵医院是国家卫生委员会批准的。为了让更..
2025-10-21 10:37 -

珠海试管婴儿三代试管医院排名如何?附试管详细信息
珠海三代试管医院排名如何?附试管详细信息。对于在珠海考虑试管婴儿的家庭来说,当地的是最受关注的。为了方便人们全面系统的了解医院的相关信息,本文特别整理了2022家珠..
2025-10-22 10:50
微信分享
扫描二维码分享到微信或朋友圈